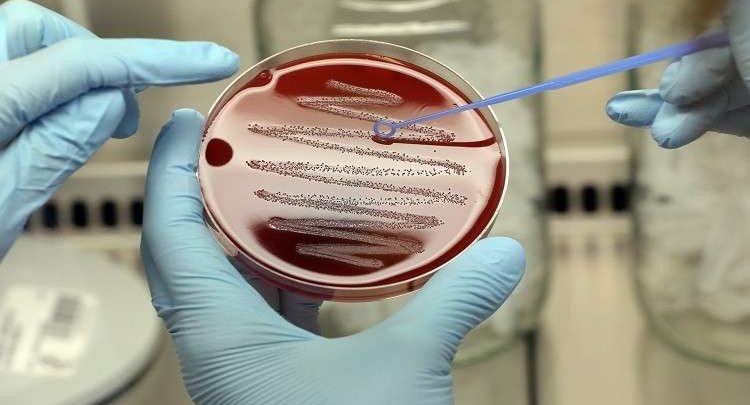

علماء يابانيون يقطعون دابر فيروس ” الإيدز ” !
تمكن علماء يابانيون من منع تكاثر فيروس مرض نقص المناعة باستخدام تقنية “كريسبر” لتعديل الجينات.
واستهدف الباحثون اليابانيون الجينات الفيروسية “tat” و”rev”، المسؤولة عن تكاثر الإيدز، وفق ما نقلت قناة “روسيا اليوم”، وطوروا دليلا خاصا لكل من الحمض النووي لنماذج فيروس نقص المناعة الستة، وأجروا القص اللازم في الشريط الوراثي لهذه الخلايا باستخدام تقنية “كريسبر”، ومنعوا الفيروس من التكاثر.
ويأمل العلماء في استخدام هذه التكنولوجيا لمعالجة مرضى الإيدز بشكل آمن وفعال.
ونشرت مجلة “Eurek Alert” أن أكثر من 35 مليون شخص في العالم يعانون من فيروس نقص المناعة البشرية، ويمكن السيطرة على المرض عن طريق تناول أدوية خاصة المضادة للفيروسات، ولكن لا يمكن تحقيق علاج كامل لهذا المرض لأن الجينات الموجودة في الخلايا المصابة هي التي تدعم الفيروسات في الجسم.